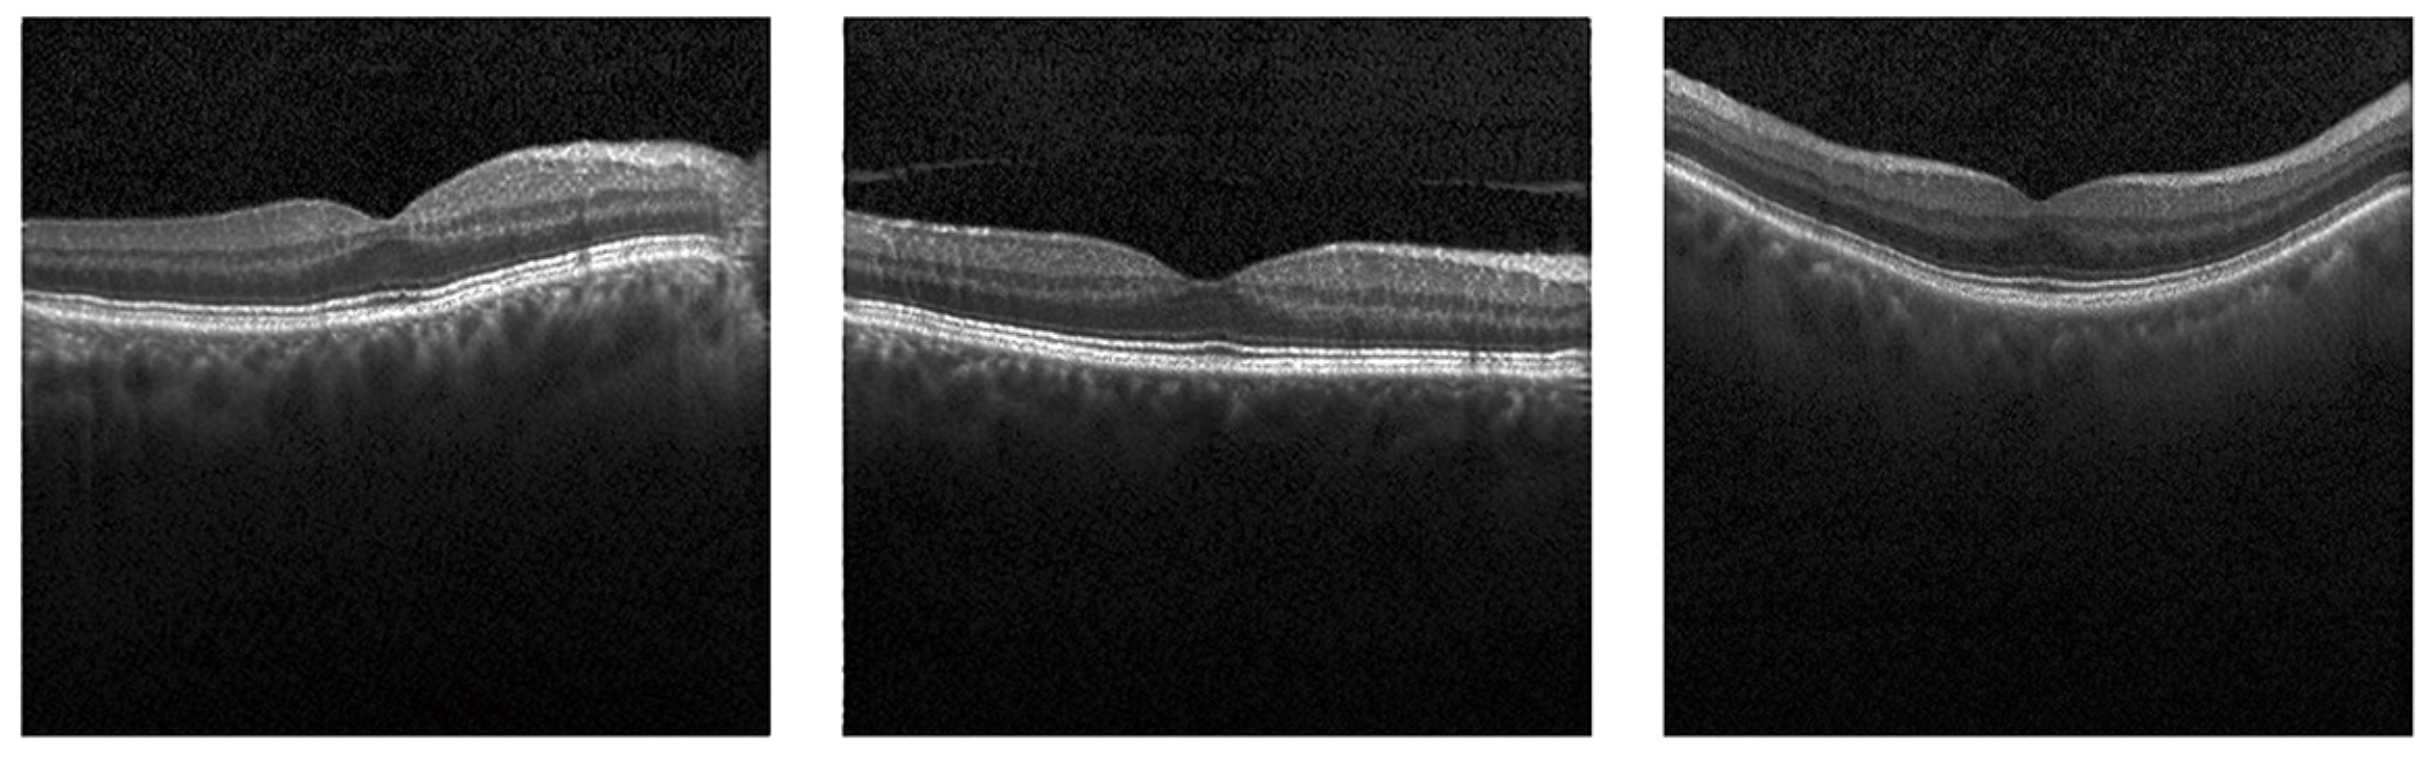

A Fast Generative Adversarial Network for High-Fidelity Optical Coherence Tomography Image Synthesis
Abstract
1. Introduction
2. Methods
2.1. FOF-GAN
2.2. Fourier Attention Block in Discriminator
2.3. FFT in Generator
2.4. Dataset
2.5. Metrics
3. Results
3.1. Image Synthesis and Evaluation
3.2. Ablation Experiments
3.3. Image Synthesis with Few Shots
4. Discussion
5. Conclusions
Author Contributions
Funding
Institutional Review Board Statement
Informed Consent Statement
Data Availability Statement
Acknowledgments
Conflicts of Interest
References
- Shamsolmoali, P.; Zareapoor, M.; Granger, E.; Zhou, H.; Wang, R.; Celebi, M.E.; Yang, J. Image synthesis with adversarial networks: A comprehensive survey and case studies. Inform. Fusion 2021, 72, 126–146. [Google Scholar] [CrossRef]
- Kermany, D.S.; Goldbaum, M.; Cai, W.; Valentim, C.C.; Liang, H.; Baxter, S.L.; McKeown, A.; Yang, G.; Wu, X.; Yan, F.; et al. Identifying medical diagnoses and treatable diseases by image-based deep learning. Cell 2018, 172, 1122–1131. [Google Scholar] [CrossRef] [PubMed]
- McCallister, E. Guide to Protecting the Confidentiality of Personally Identifiable Information; National Institute of Standards & Technology: Gaithersburg, MD, USA, 2010; Volume 800.
- Barrows, R.C., Jr.; Clayton, P.D. Privacy, confidentiality, and electronic medical records. J. Am. Med. Inform. Assoc. 1996, 3, 139–148. [Google Scholar] [CrossRef] [PubMed]
- Wang, K.; Gou, C.; Duan, Y.; Lin, Y.; Zheng, X.; Wang, F.Y. Generative adversarial networks: Introduction and outlook. IEEE/CAA J. Autom. Sin. 2017, 4, 588–598. [Google Scholar] [CrossRef]
- Creswell, A.; White, T.; Dumoulin, V.; Arulkumaran, K.; Sengupta, B.; Bharath, A.A. Generative adversarial networks: An overview. IEEE Signal Process. Mag. 2018, 35, 53–65. [Google Scholar] [CrossRef]
- Goodfellow, I.; Pouget-Abadie, J.; Mirza, M.; Xu, B.; Warde-Farley, D.; Ozair, S.; Courville, A.; Bengio, Y. Generative adversarial networks. Commun. ACM 2020, 63, 139–144. [Google Scholar] [CrossRef]
- Mirza, M.; Osindero, S. Conditional generative adversarial nets. arXiv 2014, arXiv:1411.1784. [Google Scholar]
- Jeong, J.J.; Tariq, A.; Adejumo, T.; Trivedi, H.; Gichoya, J.W.; Banerjee, I. Systematic review of generative adversarial networks (GANs) for medical image classification and segmentation. J. Digit. Imaging 2022, 35, 1–16. [Google Scholar] [CrossRef]
- Hervella, Á.S.; Rouco, J.; Novo, J.; Ortega, M. Retinal image understanding emerges from self-supervised multimodal reconstruction. In Proceedings of the International Conference on Medical Image Computing and Computer-Assisted Intervention, Granada, Spain, 16–20 September 2018; Springer: Cham, Switzerland, 2018; pp. 321–328. [Google Scholar]
- Costa, P.; Galdran, A.; Meyer, M.I.; Niemeijer, M.; Abràmoff, M.; Mendonça, A.M.; Campilho, A. End-to-end adversarial retinal image synthesis. IEEE Trans. Med. Imaging 2017, 37, 781–791. [Google Scholar] [CrossRef]
- Yu, Z.; Xiang, Q.; Meng, J.; Kou, C.; Ren, Q.; Lu, Y. Retinal image synthesis from multiple-landmarks input with generative adversarial networks. Biomed. Eng. Online 2019, 18, 1–15. [Google Scholar] [CrossRef]
- Kamran, S.A.; Hossain, K.F.; Tavakkoli, A.; Zuckerbrod, S.L. Attention2angiogan: Synthesizing fluorescein angiography from retinal fundus images using generative adversarial networks. In Proceedings of the 2020 25th International Conference on Pattern Recognition (ICPR), Milan, Italy, 10–15 January 2021; IEEE: Piscataway Township, NJ, USA, 2021; pp. 9122–9129. [Google Scholar]
- Kamran, S.A.; Hossain, K.F.; Tavakkoli, A.; Zuckerbrod, S.L.; Baker, S.A. Vtgan: Semi-supervised retinal image synthesis and disease prediction using vision transformers. In Proceedings of the IEEE/CVF International Conference on Computer Vision, Montreal, BC, Canada, 11–17 October 2021; pp. 3235–3245. [Google Scholar]
- Petzold, A.; de Boer, J.F.; Schippling, S.; Vermersch, P.; Kardon, R.; Green, A.; Calabresi, P.A.; Polman, C. Optical coherence tomography in multiple sclerosis: A systematic review and meta-analysis. Lancet Neurol. 2010, 9, 921–932. [Google Scholar] [CrossRef] [PubMed]
- Schmitt, J.M. Optical coherence tomography (OCT): A review. IEEE J. Sel. Top. Quantum Electron. 1999, 5, 1205–1215. [Google Scholar] [CrossRef]
- Povazay, B.; Hermann, B.M.; Unterhuber, A.; Hofer, B.; Sattmann, H.; Zeiler, F.; Morgan, J.E.; Falkner-Radler, C.; Glittenberg, C.; Binder, S.; et al. Three-dimensional optical coherence tomography at 1050 nm versus 800 nm in retinal pathologies: Enhanced performance and choroidal penetration in cataract patients. J. Biomed. Opt. 2007, 12, 041211. [Google Scholar] [CrossRef] [PubMed][Green Version]
- Schmidt-Erfurth, U.; Leitgeb, R.A.; Michels, S.; Povazay, B.; Sacu, S.; Hermann, B.; Ahlers, C.; Sattmann, H.; Scholda, C.; Fercher, A.F.; et al. Three-dimensional ultrahigh-resolution optical coherence tomography of macular diseases. Investig. Ophthalmol. Vis. Sci. 2005, 46, 3393–3402. [Google Scholar] [CrossRef][Green Version]
- Kande, N.A.; Dakhane, R.; Dukkipati, A.; Yalavarthy, P.K. SiameseGAN: A generative model for denoising of spectral domain optical coherence tomography images. IEEE Trans. Med. Imaging 2020, 40, 180–192. [Google Scholar] [CrossRef]
- Chen, Z.; Zeng, Z.; Shen, H.; Zheng, X.; Dai, P.; Ouyang, P. DN-GAN: Denoising generative adversarial networks for speckle noise reduction in optical coherence tomography images. Biomed. Signal Process. Control 2020, 55, 101632. [Google Scholar] [CrossRef]
- Sun, Y.; Wang, J.; Shi, J.; Boppart, S.A. Synthetic polarization-sensitive optical coherence tomography by deep learning. NPJ Digit. Med. 2021, 4, 1–7. [Google Scholar] [CrossRef]
- Zha, X.; Shi, F.; Ma, Y.; Zhu, W.; Chen, X. Generation of retinal OCT images with diseases based on cGAN. In Proceedings of the Medical Imaging 2019: Image Processing, SPIE, San Diego, CA, USA, 19–21 February 2019; Volume 10949, pp. 544–549. [Google Scholar]
- Zheng, C.; Xie, X.; Zhou, K.; Chen, B.; Chen, J.; Ye, H.; Li, W.; Qiao, T.; Gao, S.; Yang, J.; et al. Assessment of generative adversarial networks model for synthetic optical coherence tomography images of retinal disorders. Transl. Vis. Sci. Technol. 2020, 9, 29. [Google Scholar] [CrossRef]
- Liu, B.; Zhu, Y.; Song, K.; Elgammal, A. Towards faster and stabilized gan training for high-fidelity few-shot image synthesis. In Proceedings of the International Conference on Learning Representations, Vienna, Austria, 4 May 2021. [Google Scholar]
- Lichtenegger, A.; Salas, M.; Sing, A.; Duelk, M.; Licandro, R.; Gesperger, J.; Baumann, B.; Drexler, W.; Leitgeb, R.A. Reconstruction of visible light optical coherence tomography images retrieved from discontinuous spectral data using a conditional generative adversarial network. Biomed. Opt. Express 2021, 12, 6780–6795. [Google Scholar] [CrossRef]
- Qiao, C.; Li, D.; Guo, Y.; Liu, C.; Jiang, T.; Dai, Q.; Li, D. Evaluation and development of deep neural networks for image super-resolution in optical microscopy. Nat. Methods 2021, 18, 194–202. [Google Scholar] [CrossRef]
- Drexler, W.; Fujimoto, J.G. Optical Coherence Tomography: Technology and Applications; Springer: Berlin/Heidelberg, Germany, 2015; Volume 2. [Google Scholar]
- Nassif, N.; Cense, B.; Park, B.; Pierce, M.; Yun, S.; Bouma, B.; Tearney, G.; Chen, T.; De Boer, J. In vivo high-resolution video-rate spectral-domain optical coherence tomography of the human retina and optic nerve. Opt. Express 2004, 12, 367–376. [Google Scholar] [CrossRef] [PubMed]
- Simonyan, K.; Zisserman, A. Very deep convolutional networks for large-scale image recognition. arXiv 2014, arXiv:1409.1556. [Google Scholar]
- Heusel, M.; Ramsauer, H.; Unterthiner, T.; Nessler, B.; Hochreiter, S. Gans trained by a two time-scale update rule converge to a local nash equilibrium. Adv. Neural Inf. Process. Syst. 2017, 30, 1–12. [Google Scholar]
- Baur, C.; Albarqouni, S.; Navab, N. MelanoGANs: High resolution skin lesion synthesis with GANs. arXiv 2018, arXiv:1804.04338. [Google Scholar]
- Chan, K.K.; Tang, S. High-speed spectral domain optical coherence tomography using non-uniform fast Fourier transform. Biomed. Opt. Express 2010, 1, 1309–1319. [Google Scholar] [CrossRef]
- Cheong, H.; Devalla, S.K.; Chuangsuwanich, T.; Tun, T.A.; Wang, X.; Aung, T.; Schmetterer, L.; Buist, M.L.; Boote, C.; Thiéry, A.H.; et al. OCT-GAN: Single step shadow and noise removal from optical coherence tomography images of the human optic nerve head. Biomed. Opt. Express 2021, 12, 1482–1498. [Google Scholar] [CrossRef]
- Arjovsky, M.; Bottou, L. Towards principled methods for training generative adversarial networks. arXiv 2017, arXiv:1701.04862. [Google Scholar]

| Normal | DME | Drusen | |
|---|---|---|---|
| Original dataset | 99.4% | 99.2% | 98.4% |
| Baseline | 97.5% | 89.1% | 94.2% |
| Ours | 99.7% | 91.6% | 96.4% |
| Ablation Experiments | FID | Accuracy |
|---|---|---|
| Experiment I | 50.73 | 96.9% |
| Experiment II | 133.38 | 89.0% |
| Experiment III | 39.41 | 99.7% |
Publisher’s Note: MDPI stays neutral with regard to jurisdictional claims in published maps and institutional affiliations. |
© 2022 by the authors. Licensee MDPI, Basel, Switzerland. This article is an open access article distributed under the terms and conditions of the Creative Commons Attribution (CC BY) license (https://creativecommons.org/licenses/by/4.0/).
Share and Cite
Ge, N.; Liu, Y.; Xu, X.; Zhang, X.; Jiang, M. A Fast Generative Adversarial Network for High-Fidelity Optical Coherence Tomography Image Synthesis. Photonics 2022, 9, 944. https://doi.org/10.3390/photonics9120944
Ge N, Liu Y, Xu X, Zhang X, Jiang M. A Fast Generative Adversarial Network for High-Fidelity Optical Coherence Tomography Image Synthesis. Photonics. 2022; 9(12):944. https://doi.org/10.3390/photonics9120944
Chicago/Turabian StyleGe, Nan, Yixi Liu, Xiang Xu, Xuedian Zhang, and Minshan Jiang. 2022. "A Fast Generative Adversarial Network for High-Fidelity Optical Coherence Tomography Image Synthesis" Photonics 9, no. 12: 944. https://doi.org/10.3390/photonics9120944
APA StyleGe, N., Liu, Y., Xu, X., Zhang, X., & Jiang, M. (2022). A Fast Generative Adversarial Network for High-Fidelity Optical Coherence Tomography Image Synthesis. Photonics, 9(12), 944. https://doi.org/10.3390/photonics9120944

